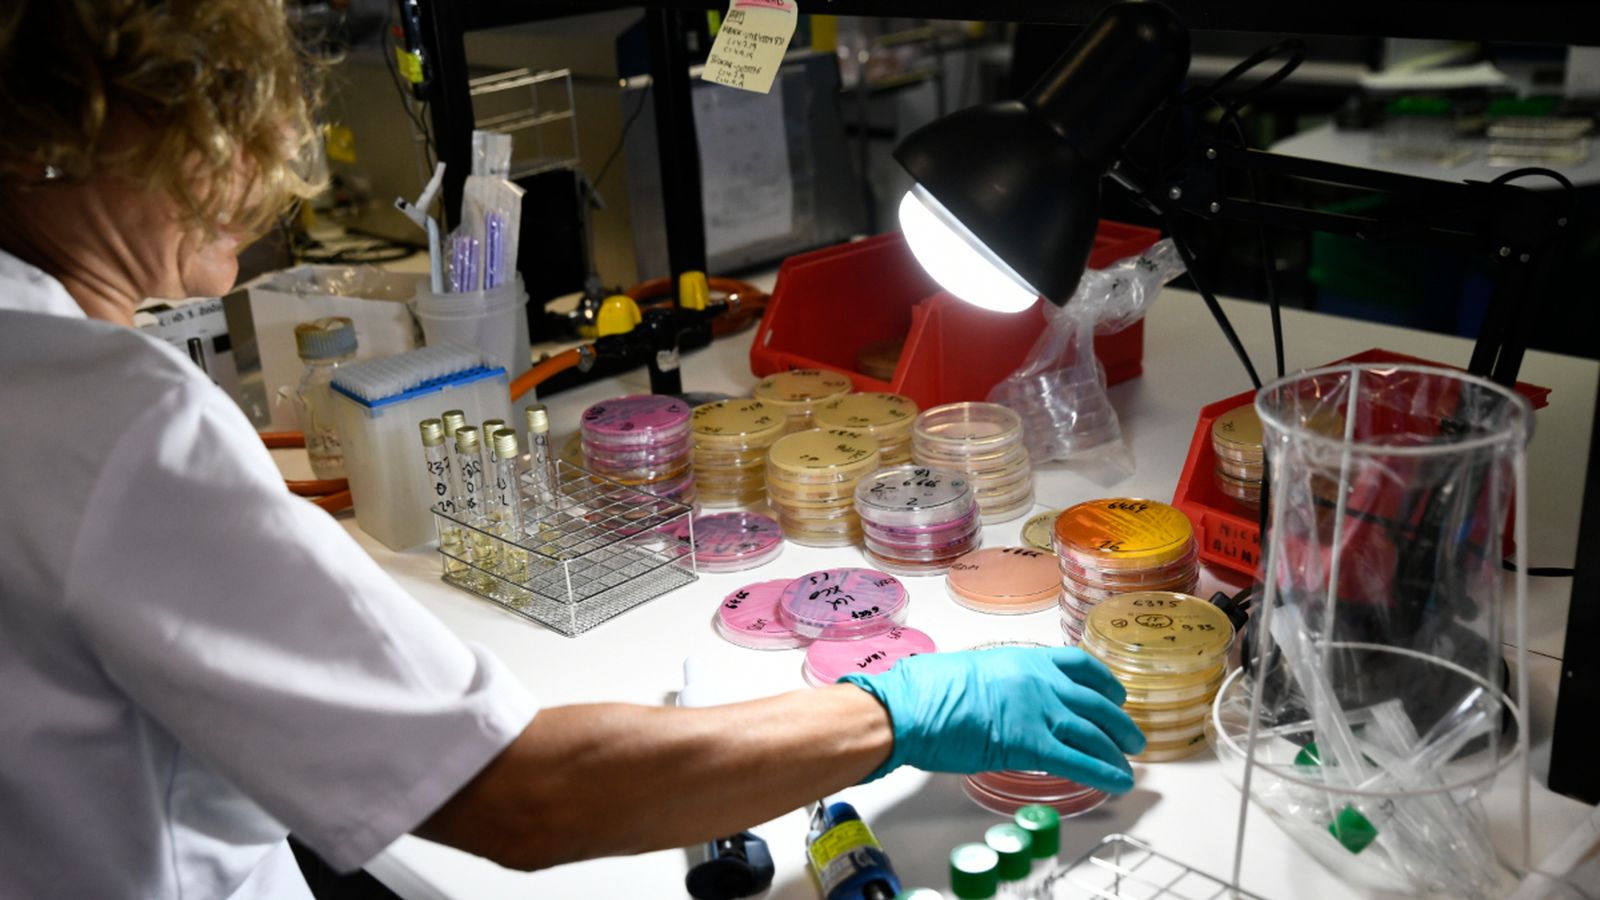
Una investigadora treballa al Laboratori Regional de Salut Pública de la Comunitat de Madrid

Espanya inverteix “pocs recursos” a posar fi a la bretxa de gènere en la ciència
Un estudi fet en sis països revela que s’inverteix menys que a Àustria o Alemanya, però reconeix la “rica experiència” en plans d’igualtat.
A Espanya, la quantitat de recursos destinats a posar fi a la bretxa de gènere en la ciència i el sector I D és inferior a la d’Àustria, Alemanya o els països nòrdics. No obstant això, presenta un dels marcs legislatius més desenvolupats en matèria d’igualtat de gènere.
Són les conclusions extretes de l’estudi Evaluation and Program Planning, dirigit per l’organització alemanya Fraunhofer, en el qual participen la Universitat Oberta de Catalunya (UOC) i la Universitat d’Aarhus (Dinamarca). Malgrat les carències, la investigadora Rachel Palmén ha indicat que Espanya té una “rica experiència” en el desenvolupament de plans d’igualtat de gènere i algunes de les veus expertes més famoses d’Europa en aquesta àrea.
La investigació va analitzar la implementació de les mesures d’igualtat de gènere tenint en compte diversos paràmetres, entre d’altres qui assumeix les responsabilitats, les relacions amb els òrgans de decisions i si les barreres que hi havia es podien superar. Els resultats van revelar que, a banda de la falta de recursos per a revertir la situació, és necessari que les plantilles tinguen competències en gènere perquè aquestes mesures d’igualtat siguen efectives.
D’altra banda, la investigació ha posat en relleu una idea molt estesa basada en el fet que la igualtat de gènere es limita a igualar el nombre de dones i homes en una empresa o institució. “També implica pensar en com els processos en l’àmbit institucional poden promoure o reduir el biaix de gènere”, ha indicat la investigadora. En el cas concret dels sectors I D, les mesures van un pas més enllà i abasten la qüestió de gènere en la investigació i la innovació. “Les intervencions d’igualtat en I D són complexes i qualsevol avaluació les ha de tindre en compte”, planteja Palmén.
